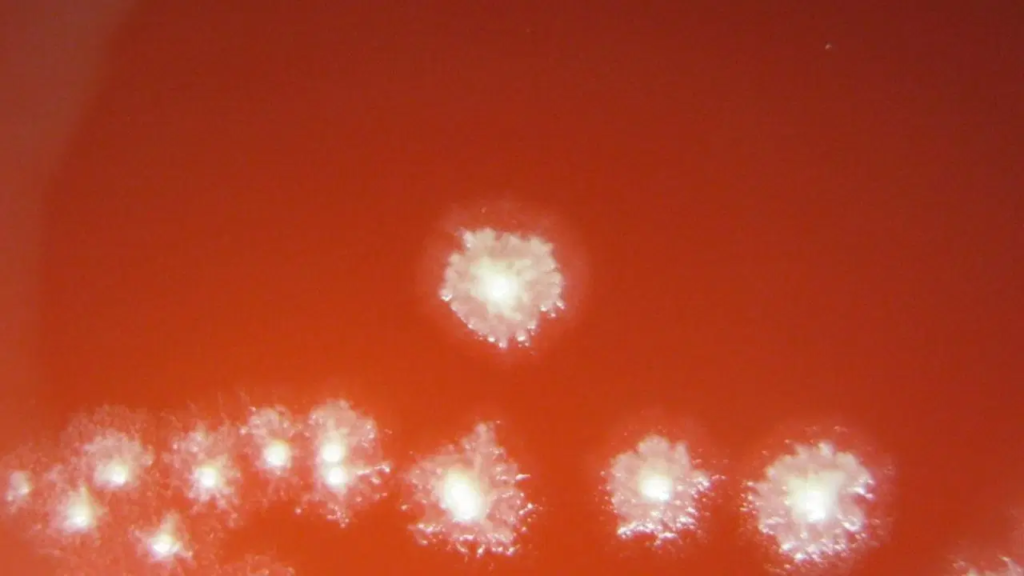

Bilim insanları, kanser tedavisinde çığır açabilecek bir yöntemi hayata geçirdi. Genetik olarak tasarlanan toprak bakterileri, tümörlerin oksijensiz bölgelerine girerek kanserli dokuyu içeriden parçalayarak yok ediyor.
Onkoloji dünyası, kanserli hücreleri doğrudan hedef alan “akıllı” bir biyolojik silahın heyecanını yaşıyor. Geleneksel kemoterapi ve radyoterapi yöntemlerinin aksine, doğrudan tümörün kalbine sızan bu yeni yöntem, katı tümörlerin en büyük zayıf noktasını hedef alıyor. Araştırmacılar, toprakta doğal olarak bulunan Clostridium sporogenes bakterisini genetik mühendisliği ile yeniden kodlayarak, kanserli kitleleri tamamen yok edebilecek bir “yiyici” organizmaya dönüştürdü.
Kanser Hücrelerinin İçinde Oksijensiz Bölge: Bakterilerin Hedefi
Birçok katı tümör türü, hızla büyürken kendi kan desteğini aşar ve merkezinde oksijensiz bir bölge oluşur. Bilim insanları, sadece oksijensiz ortamlarda hayatta kalabilen Clostridium sporogenes bakterisinin bu alanı ideal bir üreme merkezi olarak kullandığını saptadı. Tümörün içine sızan bakteriler, burada hızla çoğalarak kanserli dokuyu parçalamaya başlıyor. Ancak geçmiş çalışmalarda bu bakterilerin tümörün oksijenli dış çeperine ulaştığında ölmesi, tedavinin yarım kalmasına neden oluyordu. Waterloo Üniversitesi ekibi, bu sorunu genetik bir müdahaleyle aşmayı başardı.
Kanser Tedavisinde Oksijen Bariyerini Yıkan Genetik Yaklaşım
Kimya Mühendisi Profesör Marc Aucoin liderliğindeki ekip, bakteriye oksijene karşı direnç sağlayan özel bir gen ekledi. Bu genetik modifikasyon sayesinde bakteriler, tümörün sadece merkezinde hapsolmayacak, oksijen seviyesinin yükseldiği dış bölgelerde de hayatta kalarak tümörü tamamen temizleyebilecek. Ancak bu durum, bakterilerin kan dolaşımı gibi oksijenin bol olduğu sağlıklı bölgelerde de çoğalabileceği riskini doğurdu. Araştırmacılar, bu tehlikeyi önlemek için bakterilere bir “karar verme” mekanizması yükledi.
Kanser Tedavisinde Kontrollü Yaklaşım: Kitle Algılama Sistemi
Bakterilerin vücudun sağlıklı bölgelerine zarar vermesini engellemek amacıyla “kitle algılama” (quorum sensing) adı verilen bir iletişim sisteminden yararlanıldı. Bu sistem sayesinde, oksijene dayanıklılık geni ancak bakteri popülasyonu tümör içinde belirli bir yoğunluğa ulaştığında aktif hale geliyor. Böylece bakteriler, kan dolaşımı gibi düşük yoğunlukta bulundukları sağlıklı alanlarda pasif kalırken, tümörün içinde sayıları arttığında “savaşçı” moduna geçiyor.
Yapılan testlerde, genetik olarak modifiye edilen bakterilerin sadece hedeflenen yoğunluğa ulaştığında aktifleştiği floresan proteinler aracılığıyla kanıtlandı. Bilim heyeti, bir sonraki aşamada bu sistemi pre-klinik tümör modellerinde test etmeye hazırlanıyor.
06.03.2026 18:28















